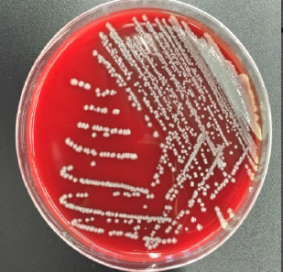
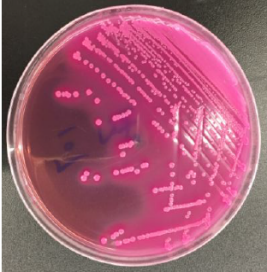

從經(jīng)驗醫(yī)療轉(zhuǎn)化為循證醫(yī)學的過程,是獸醫(yī)界同仁們都在經(jīng)歷的過程。
在微生物感染的治療中,循證醫(yī)學的理論不僅告訴我們?nèi)魏吾t(yī)療決策都應建立在最佳科學研究證據(jù)基礎上,還可以讓我們更有意識的有效控制抗生素濫用,以免超級細菌的產(chǎn)生。

隨著微生物檢測工作的技術與理論的普及,許多獸醫(yī)開始認識到微生物感染時進行微生物培養(yǎng)與藥敏試驗的重要性。藥敏試驗目的是篩選敏感抗生素以達到有效的抗菌治療,從而縮短治療周期,減少動物痛苦。
臨床醫(yī)師應根據(jù)藥敏試驗結(jié)果,合理選用有療效的藥物進行治療,才能收到良好的療效,藥敏試驗也是院內(nèi)感染和流行病學調(diào)查的有力手段之一,可監(jiān)視耐藥菌株的逐年藥敏動態(tài)變化,有助于醫(yī)院制定防治方案,避免用藥不當而產(chǎn)生耐藥菌株或增強原有耐藥菌株耐藥性,給治療帶來困難。
目前寵物臨床診療中,經(jīng)驗性選擇藥物還是比較常見的,一旦機體產(chǎn)生耐藥后,再考慮藥敏實驗有可能已經(jīng)錯過治療的最佳時期。
目前,拓瑞實驗室可進行細菌常規(guī)培養(yǎng)、鑒定與藥敏試驗,酵母樣真菌培養(yǎng)、鑒定與藥敏試驗,皮膚病原真菌檢測,這三類常見微生物檢測手段。
本文主要闡述細菌培養(yǎng)與藥敏的報告解讀、臨床常見困惑答疑、治療效果和體外藥敏不一致的原因 。
細菌常規(guī)培養(yǎng)(屬于有氧培養(yǎng)),是針對各種常見病原菌的一種檢測方法。使用體外試驗的方法檢測可能致病的病原菌。通過劃線分離培養(yǎng)(圖1)、增菌培養(yǎng)、可疑菌落純培養(yǎng)并運用選擇培養(yǎng)基的選擇性(圖2),以此方法培養(yǎng)出可疑病原菌。
進一步通過革蘭氏染色將細菌分為兩類:革蘭陽性菌、革蘭陰性菌;通過鏡下形態(tài)觀察,確定是否為革蘭陽性球菌或革蘭陰性桿菌(圖3)。
下一步,會通過初步的觸酶試驗,將革蘭陽性球菌分為葡萄球菌屬和鏈球菌屬;通過氧化酶和O/F發(fā)酵試驗將革蘭陰性桿菌分為腸桿菌屬和非發(fā)酵菌屬。最后在細菌鑒定與藥敏分析儀中進行最終的生化鑒定(圖4 )。
圖 1 腸桿菌屬在血瓊脂上形態(tài)
圖 2 大腸埃希菌在MAC上形態(tài)

圖 3 革蘭陽性鏈球菌

圖 4 可報告菌部分節(jié)選
細菌鑒定結(jié)果確定后,將會進行針對該菌種的藥物選擇以及藥敏試驗。實驗室參照美國實驗室標準委員會(NCCLs)的最新標準進行藥敏試驗。根據(jù)不同病原菌、病原菌所在部位和給藥途徑,以及藥代動力學選擇有代表性的藥物做藥敏試驗。將藥敏試驗分為首選藥、次選藥和尿路感染藥物。
首選藥是針對不同病原菌的最佳選擇,次選藥是患寵對首選藥不敏感或患寵對該藥過敏或禁忌使用的情況下選用,尿路感染只限于尿路感染時選用。

圖5 一株MRS陰性的葡萄球菌的藥敏試驗報告
報告解讀:
A組 包括常規(guī)報告、首選試驗的藥物組合,以及一些對特定菌群的常規(guī)試驗報告。
B組 包含一些可以用于首選試驗的藥物。但是,它們只是被選擇性地報告,例如當細菌對A組同類藥物耐藥時,可以選用。
C組 包括替代性或補充性抗微生物藥物,可在以下情況進行試驗:某些單位機構內(nèi)潛伏有對一種或數(shù)種基本藥物(特別是對同類的,如β-內(nèi)酰胺類)耐藥的,局部流行或廣泛流行的菌株;治療對首選藥物過敏的患者;治療少見菌的感染(如氯霉素對腸道外感染沙門菌屬分離株或某些對萬古霉素耐藥的腸球菌);或有助于流行病學的感染控制報告。
U組 (“泌尿道”) 列出了某些僅用于治療泌尿道感染的抗微生物藥(如呋喃妥因和某些喹諾酮類藥物)。除泌尿道外,其它感染部位分離的病原菌不用此組藥物進行試驗。其他有更廣泛適應癥的藥物可以包括在U 組中用于治療特殊的泌尿道病原菌(如,銅綠假單胞菌)。
O組 ( “其它” ) 對該組細菌有臨床適應癥,但在美國一般不常規(guī)試驗與報告的候選。
Inv 組( “研究性” ) 對該菌群作研究用且尚未經(jīng)FDA批準的藥物。
對于結(jié)果通常使用敏感(S)、中介(I)、耐藥(R)來表現(xiàn)。報告中的敏感、中介或耐藥,其定義如下:
敏感(S)“敏感”類 表示當對感染部位使用推薦劑量時,該菌株通常被抗微生物藥物濃度可達到的水平所抑制。
中介(I)“中介”類 包括這些菌株,其抗微生物藥物MIC 接近于血液和組織中通?蛇_到的水平,而抗微生物藥治療的反應率可能低于敏感株。“中介”分類意味著藥物在生理濃集部位具有臨床效力(如尿液中的喹諾酮類和β-內(nèi)酰胺類)或者可用高于正常劑量的藥物進行治療(如β-內(nèi)酰胺類)。此分類還包括一個緩沖區(qū),它可以避免微小的、未能控制的技術因素造成重大的結(jié)果解釋錯誤,特別是對那些藥物毒性范圍窄的藥物。
耐藥(R) “耐藥”類 是指按常規(guī)劑量表,在抗微生物藥通?蛇_到的濃度時,菌株不能被抑制;或/和表明抑菌圈直徑縮小到菌株可能產(chǎn)生了特殊的微生物耐藥機制(如β-內(nèi)酰胺酶)的范圍內(nèi),并且治療研究顯示藥物對菌株臨床療效并不可靠。
當需要對報告進行解讀時,需要注意以下幾點:
?. 細菌自動分析儀的藥敏組合是固定的。(所以我們需要進行菌種鑒定,因為每種菌所對應的藥物選擇是不同的)
?. 某些細菌對某類藥物存在天然耐藥,則不需要做藥物敏感試驗。(如腸球菌對頭孢天然耐藥,再次印證對于不同菌的抗生素選擇很重要,如果盲目的去做藥物敏感試驗,有時結(jié)果可能并不能反映真正的情況)
?. 試驗的藥物代表的是一類藥物,而不是只代表該種藥物。(例如 圖6 中,青霉素與苯唑西林可以預測大部分β-內(nèi)酰胺類藥物,并檢測是否存在多重耐藥)
?. 因為是體外藥敏試驗,有些藥物體外敏感,可能臨床治療無效
?. 同一菌株可能出現(xiàn)亞種,導致連續(xù)藥敏試驗不同。(所以非相同標本的藥敏試驗進行實驗室間對比并無意義)

再一起看看實驗室與臨床溝通時常見的問題
集合 7個臨床常見困惑 解答
Q1:為什么我們想用的藥物在藥敏試驗中沒有做?
A1:1)可能為天然耐藥;2)可能是藥物敏感性被其他藥物所預報。
Q2:為什么有的細菌報告很多種藥物,有的僅報告幾種?
A2:報告的藥物種類由細菌種類決定,如銅綠假單胞菌報告的藥物種類多,而嗜麥芽窄食單胞菌報告的藥物種類少。(再次強調(diào)菌種鑒定的重要性)
Q3:是否能將使用的藥都做藥敏試驗?
A3:沒有必要也不太可能。
1)通過耐藥機制和標志性藥物可以預報其他抗菌藥物敏感性;
2)并不是所有藥都可以做藥敏試驗,需要藥物在體內(nèi)穩(wěn)定,并具有操作標準和解釋標準才可。
Q4:培養(yǎng)陽性的細菌都需要進行抗生素治療嗎?
A4:培養(yǎng)陽性≠感染,可能為污染菌或定植菌,任何結(jié)果需要結(jié)合臨床情況進行評價。感染部位的清創(chuàng)、引流、換藥有時要比藥物治療更加重要……
Q5:為什么藥敏試驗敏感的藥物,在臨床治療中無效?
A5:體外藥敏試驗只能預測體內(nèi)治療效果,可以理解為耐藥=治療無效。
敏感≠治療有效。
其原因可能為: 1)可能不是真正的致病菌,(污染菌或定植菌);2)細菌本身產(chǎn)生誘導耐藥機制或生物被膜;3)感染部位與藥代動力學因素;4)細菌的MIC,給藥的劑量和給藥方式因素;5)藥敏試驗中有些藥物單獨使用無效,需要其他抗生素聯(lián)合用藥; 6)藥物劑型及生物利用度因素。
Q6:涂片鏡檢結(jié)果與培養(yǎng)結(jié)果不吻合?
A6:1)涂片鏡檢為所有可檢見的細菌。而培養(yǎng)的目的在于檢出致病菌;2)一些苛養(yǎng)菌需在特殊環(huán)境下才可生長。
Q7:取的明顯就是膿液標本,報告為何是陰性?
A7:1)實驗室目前開展的為常規(guī)微生物培養(yǎng),是有氧培養(yǎng),如果為厭氧菌感染則培養(yǎng)陰性;2)可能細菌被大量中性粒細胞吞噬。
準確判讀與規(guī)范操作

由于機體處于復雜的微生態(tài)環(huán)境,微生物培養(yǎng)、鑒定、藥敏試驗的結(jié)果解讀對臨床意義重大。
在臨床工作中,需規(guī)范送檢、運送、培養(yǎng)、鑒定、藥敏流程。每個細節(jié)都會對結(jié)果造成巨大影響。如診斷導管相關感染時,臨床需同時送檢外周血培養(yǎng)和導管血,必要時送檢導管尖。但臨床對血培養(yǎng)的送檢量、頻率、時機,概念不是特別清楚。
而微生物室對結(jié)果判讀、解釋缺乏有效的機制。例如正確的導管尖端培養(yǎng)結(jié)果解讀應當是:菌落計數(shù)>15 CFU(提示CRS),包括G+b;進行鑒定、藥敏;菌落計數(shù)<15 CFU,僅鑒定一種重要的菌(如白念、A群、G-b);如菌量太大,報告>100 CFU,當分離出金葡或G-b時,而未送血培養(yǎng),應建議“請送血培養(yǎng)以診斷是否發(fā)生導管相關感染”。半定量平皿96h出報告(要參照血培養(yǎng))。
▼治療效果和體外藥敏不一致的原因
1. 抗菌藥物的應用會明顯降低培養(yǎng)的陽性率。強調(diào)在使用抗生素前留取標本。
2. 標本的正確采集和運輸常常是微生物診斷技術成功的關鍵所在。以痰培養(yǎng)為例,通過涂片鏡檢發(fā)現(xiàn)不合格者不做培養(yǎng),合格標本培養(yǎng)在3+~4+的菌才有可能是致病菌。血培養(yǎng)檢查標準的采血方式是每個穿刺部位分別接種需氧和厭氧兩個瓶子,至少2個穿刺點,寒戰(zhàn)前1h抽血的陽性率較高。罕見的病原菌如放線菌、奴卡菌引起的皮膚軟組織感染,組織標本培養(yǎng)的陽性率明顯高于單純膿液的培養(yǎng)。標本需及時送達實驗室并及時處理,否則會造成假陰性或假陽性的結(jié)果。
3. 雖然無菌體液如血、腦脊液較呼吸道標本更可信,但無菌部位的培養(yǎng)也可能會污染。凝固酶陰性葡萄球菌已成為血和無菌體液培養(yǎng)中最常見的病原菌,有數(shù)據(jù)顯示其污染率高達80%以上。
4. 呼吸道標本在判斷污染或感染時常感困難。很多念珠菌可能只是定植而不是感染,需要結(jié)合臨床判斷。
5. 微生物學檢查結(jié)果需詳細了解送檢標本的質(zhì)量、次數(shù)、病原檢出時間、不同部位的培養(yǎng)結(jié)果等,同時結(jié)合臨床表現(xiàn)綜合判斷。
6. 藥敏判定折點需要及時更新,特別要參照美國CLSI文件。